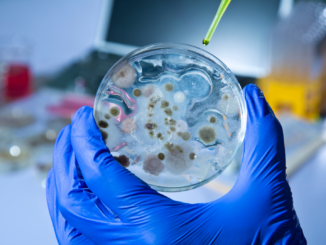
Studie: 1,2 Millionen Menschen starben 2019 durch multiresistente Erreger

WHO: 99 Prozent aller Menschen leiden unter Luftverschmutzung
99 Prozent der Menschen auf der Erde atmen Luft ein, die zu viele Schadstoffe enthält. Wie ein am Montag vorgelegter Bericht der Weltgesundheitsorgansation (WHO) zeigt, hat inzwischer jeder Winkel der Welt mit Luftverschmutzung zu kämpfen. […]